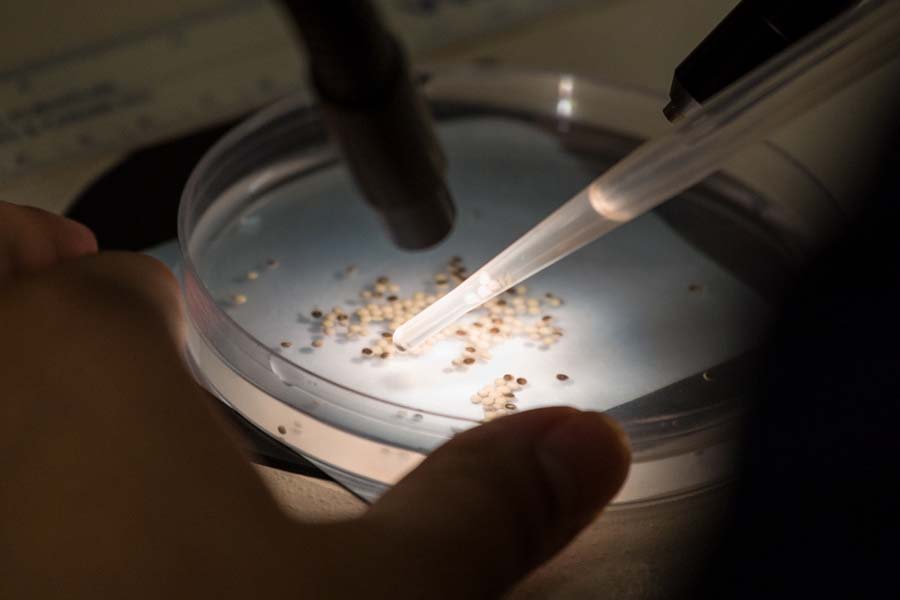

Knox Stories
Michael Takeo Magruder Named First Knight Fund Distinguished Artist-in-Residence
Knox College will host its first-ever Knight Fund Distinguished Artist-in-Residence, Michael Takeo Magruder, from September 16 to September 30, 2025
Venture Boldly

Office of Communications
2 East South Street
Galesburg, IL 61401


Plastic straws have lost the battle and they've been banished from the Knox College campus. As first reported by the Knox College Office of Sustainability on the office's Facebook page on April 25, paper drinking straws have replaced plastic in all of Knox's Dining Services facilities.
The move — which makes Knox the third college in the nation to ban plastic straws — was initiated by a request from the Student Senate Sustainability Committee to Bon Appetit, which manages Dining Services on campus.
News media coverage has included:
Above, students in a history course use plastic "straws" to re-enact ancient Greek warfare. Below, three areas on campus where paper straws will not be used: underground drainage, holding the tarp for the baseball field, and in the science lab...

Published on June 08, 2018

 The victors tower over the vanquished
The victors tower over the vanquished